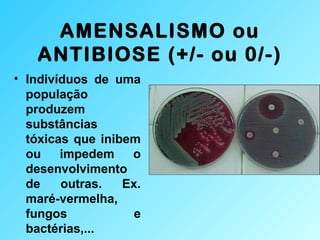
AMENSALISMO ou
ANTIBIOSE (+/- ou 0/-)
• Indivíduos de uma
população
produzem
substâncias
tóxicas que inibem
ou impedem o
desenvolvimento
de outras. Ex.
maré-vermelha,
fungos e
bactérias,...

O documento descreve as principais relações ecológicas entre populações, incluindo relações harmônicas como mutualismo, comensalismo e inquilinismo, e relações desarmônicas como competição, canibalismo e parasitismo. Ele também fornece exemplos detalhados de sociedades de insetos como abelhas, formigas e cupins.